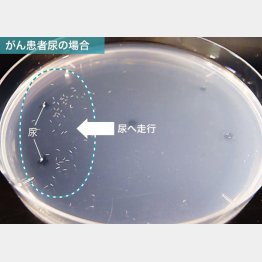

線虫がん検査<下>見分けられる感度は85%以上 自宅で完結
新型コロナウイルスの感染拡大の影響で、昨年がん検診を受けた人が前年に比べて約3割減少したことが「日本対がん協会」の調査で分かっている。感染を心配した「受診控え」が減少の要因で、本来であれば発見されるべきがんが見過ごされ、今後進行がんとなって見つかる割合が増加することが懸念されている。
そんな状況において、医療機関に行かなくても自宅で簡単にがんリスクが調べられる新しい検査が登場している。「線虫がん検査(N―NOSE・アット・ホーム)」と呼ばれるがんの1次スクリーニング検査で、今年2月から東京都と福岡県で先行開始され、5月からは対象エリアを全国に拡大、7月には全47都道府県で受けられる予定という。
線虫がん検査とはどんな検査なのか。サービスを提供するバイオベンチャー「HIROTSUバイオサイエンス」(東京都千代田区)事業本部長の久保田陽一取締役が言う。
「検査では、体長約1ミリの『シー・エレガンス』という種類の線虫(糸状の細い生物)を用います。線虫は機械では検知できない微量なにおい物質を嗅ぎ分けることができ、がん患者の尿に含まれるがん特有のにおいを検知します。ですから尿を検体として提出してもらい、がんのリスクを調べる『生物診断』という検査法になります」